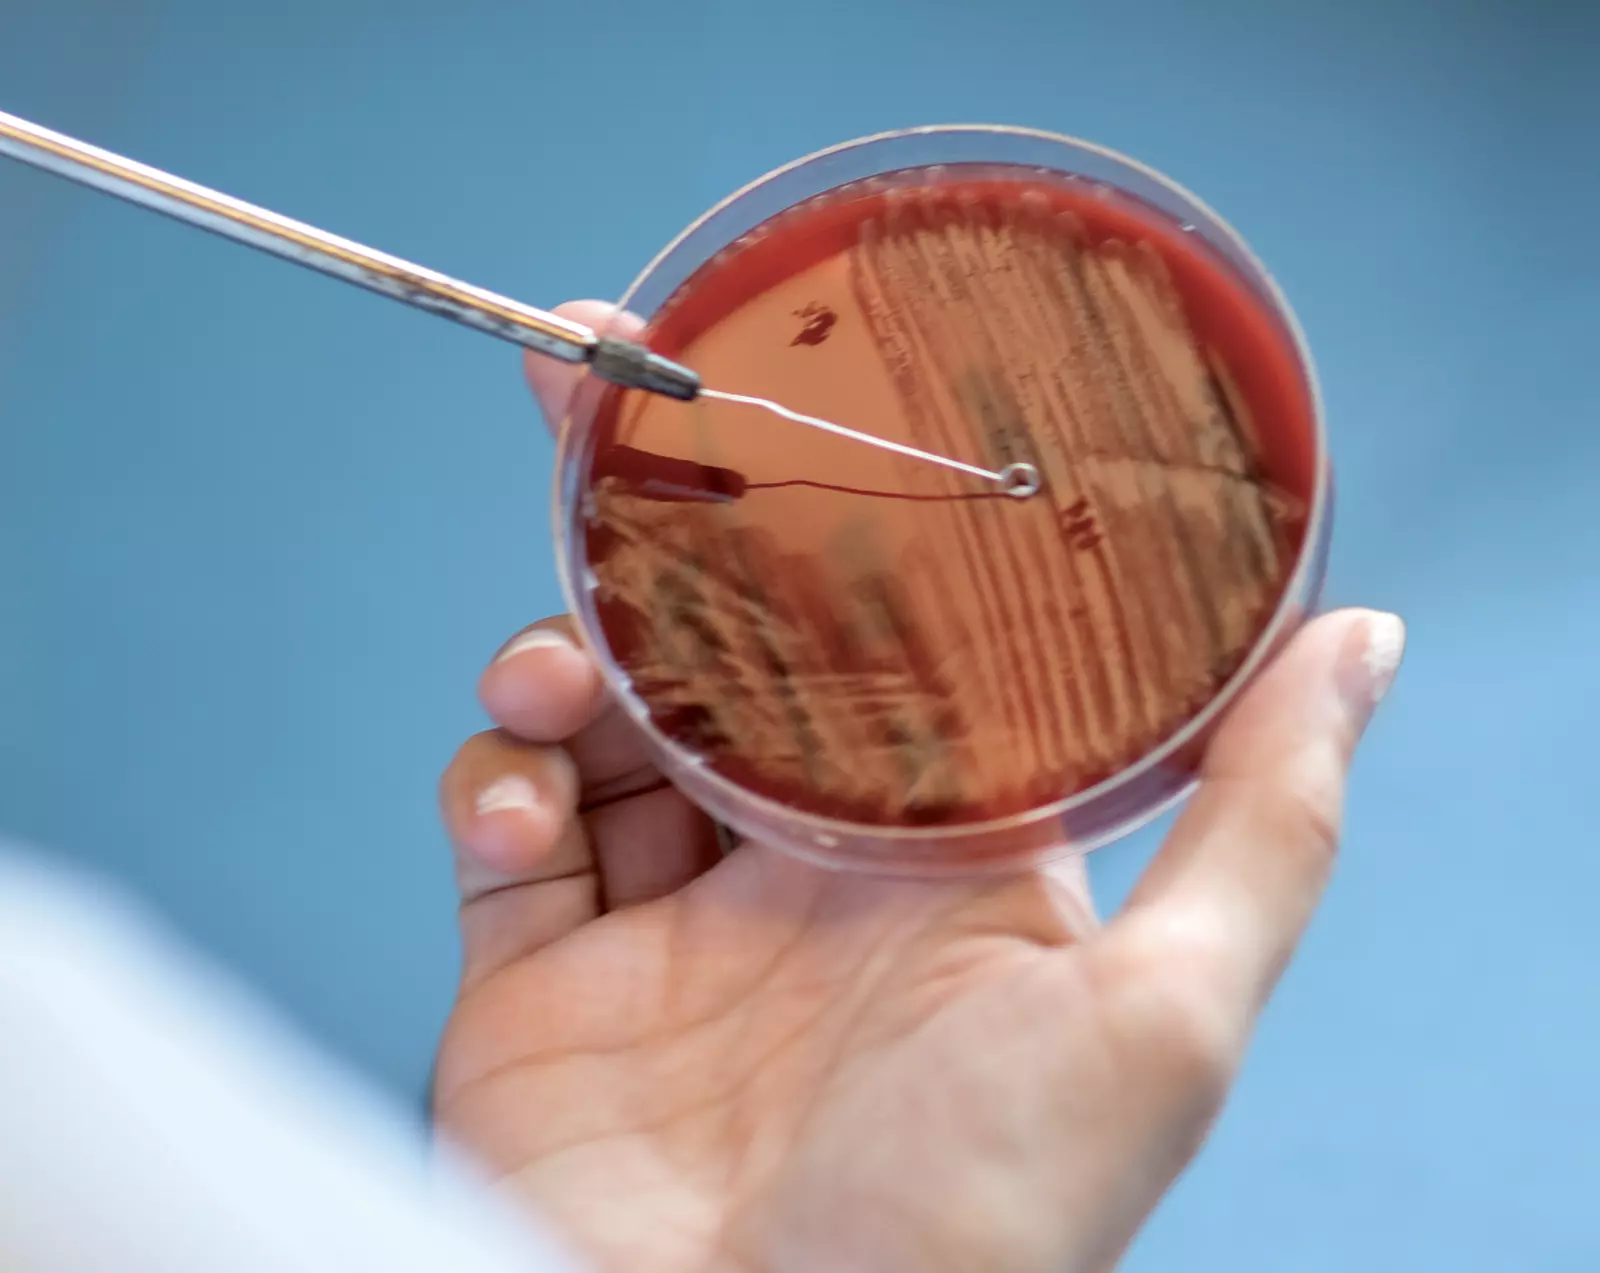

Le Conseil d’État décide de créer une nouvelle entité regroupant les établissements sanitaires cantonaux (somatiques et psychiatriques), les instituts sanitaires universitaires et les écoles cantonales de formation aux professions de la santé. Il choisit de reprendre pour cet ensemble, qui deviendra opérationnel en 1991, la dénomination de Service des Hospices cantonaux.
Création d’un Service de gériatrie rattaché au Département de médecine. Aujourd’hui, le Service de gériatrie et réadaptation gériatrique comprend notamment le Centre de traitement et de réadaptation Sylvana à Epalinges qui, après avoir œuvré comme centre antituberculeux, accomplit sa mission actuelle depuis 1994.
Inauguration de l'Institut universitaire de la médecine et de la santé publique, qui deviendra en 2018 l'Institut des humanités en médecine. Il est cogéré par le CHUV et la Faculté de biologie et de médecine de l'UNIL.
Le premier appareil d'imagerie par résonance magnétique (IRM) est mis en fonction pour les patientes et les patients en 1990.
Le premier vaccin contre le mélanome est administré en 1992 par la branche lausannoise de l’Institut Ludwig.
La première perfusion d'un membre isolé pour les sarcomes a lieu en 1992. Cette méthode thérapeutique nouvelle, développée au CHUV, permet dans bien des cas d’éviter l’amputation ou la désarticulation.
Adoption par le Grand Conseil de la Loi sur les Hospices cantonaux, conférant ainsi le cadre légal aux missions de soins, d'enseignement, de recherche et de services qui incombent à l'entité créée en 1990.
Les cantons de Vaud et de Genève créent l'Association Vaud-Genève dans le domaine de la santé publique et des Hôpitaux universitaires afin de favoriser la collaboration entre ces derniers.
L’hôpital se numérise et le premier site internet institutionnel est mis en ligne.
L’aile ouest de l'Hôpital orthopédique de la Suisse romande est inaugurée.
La Loi sur les Hospices cantonaux de 1993 fait l'objet d'une première modification. Elle introduit notamment des instruments de gestion tels que le plan stratégique et le contrat de prestations.
Signature de la convention cadre de collaboration dans le domaine hospitalier entre les cantons du Valais et de Vaud.
Inauguration du Musée de la main UNIL-CHUV.
Création en 1997-1998 de la Section des dépendances avec une unité hospitalière à Cery et un centre ambulatoire à Lausanne.
Le premier poste de ressources humaines, rattaché au Bureau de gestion du personnel, est créé.
Le Département de médecine des laboratoires voit le jour. Il est composé de l'Institut de microbiologie et de plusieurs laboratoires qui regroupent de nombreuses spécialités.
Création de la Fondation pour la recherche en soins en partenariat avec la Faculté de médecine de l’UNIL, la Croix-Rouge suisse et l’École La Source, servant de socle à ce qui deviendra l’IUFRS.
Le bénévolat est officialisé en 1999. L’équipe compte en 2022 près d’une centaine de bénévoles actifs et actives dans 22 services cliniques et unités de l’hôpital.
Le projet d'archivage électronique des dossiers «Archimede» aboutit en 1999. Il permet d’éviter la construction de nouveaux locaux de stockage de dossiers, dont le volume augmentait au rythme d’un kilomètre de rayonnages par an.
Pas de bug de l'an 2000 à l'hôpital: l’Office informatique, future Direction des systèmes d’information, a pu mettre à jour près de 140 applications et 3000 équipements techniques et médicaux dans les temps pour éviter les pannes.
La Fondation de l'Hôpital de l'Enfance, Lausanne et le CHUV créent conjointement le Département de médecine et de chirurgie pédiatriques.
Dans le cadre de la constitution de la Haute École spécialisée santé-social de la Suisse romande, les écoles de formation aux professions de la santé ont été séparées des Hospices cantonaux.
La Policlinique médicale universitaire (PMU) occupe son nouveau bâtiment sis au 44 de la rue du Bugnon, concrétisant ainsi une complémentarité entre le CHUV et la PMU dans le cadre du Département universitaire de médecine et santé communautaires.
Réorganisation du Service des Hospices cantonaux qui s'appelle désormais les Hospices-CHUV. Les trois secteurs psychiatriques y sont intégrés en tant que département.
La Faculté de médecine de l'UNIL se transforme en une Faculté de biologie et de médecine (FBM).
Le Département de psychiatrie est créé. Il regroupe les Services de psychiatrie de l’enfant, adulte et âge avancé du secteur psychiatrique Centre du canton de Vaud. Il accueille cette même année le nouveau Centre de neurosciences psychiatriques. En 2004, il intègre le Service de médecine et psychiatrie pénitentiaires. L'année 2003 voit l'inauguration de Centre de psychiatrie du nord vaudois, hôpital situé au centre-ville d'Yverdon-les-Bains.
Le Département des centres interdisciplinaires et de la logistique médicale est créé. Il a depuis été renommé Département des centres interdisciplinaires.
Le CHUV et la FBM ouvrent le Centre de transplantation d'organes. Il sera associé en 2004 avec le Service de transplantation des HUG pour former le Centre universitaire romand de transplantation.
Le CHUV reprend les activités cliniques de la Fondation de l'Hôpital de l'Enfance, Lausanne.
Le Service d'angiologie est créé. Auparavant, il était rattaché à la cardiologie jusqu’en 1996, puis avait intégré le Service d’hypertension et médecine vasculaire.
Le CHUV accueille ses premier-ères assistant-es en soins et santé communautaire. Il est alors l’une des premières institutions de soins aigus à intégrer ce nouveau profil professionnel. Il s’engage également en faveur de leur formation en tant que maître d’apprentissage.
Création du Conseil de direction UNIL-CHUV chargé des décisions ayant des aspects communs aux deux institutions et adoption par le Conseil d’État d'un règlement sur la gestion du domaine de l'enseignement et de la recherche en biologie et en médecine par l'UNIL et les Hospices cantonaux.
Comme dans le reste des lieux publics, les bâtiments du CHUV deviennent entièrement non fumeurs.


Le Service de médecine intensive adulte, issu de la fusion des Soins intensifs de médecine et de chirurgie, est rattaché au Département des centres interdisciplinaires.
Le Département de médecine se diversifie: il crée le Centre d’investigation et de recherche sur le sommeil, puis accueille le Service de médecine génétique ainsi que le Service de soins palliatifs et de support.
Création du Département de la formation et de la recherche.
Les Instituts universitaires de médecine légale de Genève et de Lausanne fusionnent pour donner naissance au Centre universitaire romand de médecine légale.
Création de l'Unité d'éthique clinique du CHUV. Elle est spécialisée dans l’accompagnement et le dialogue rapproché avec les patient-es les plus malades, leurs proches et les professionnel-les pour la détermination du projet de soins.